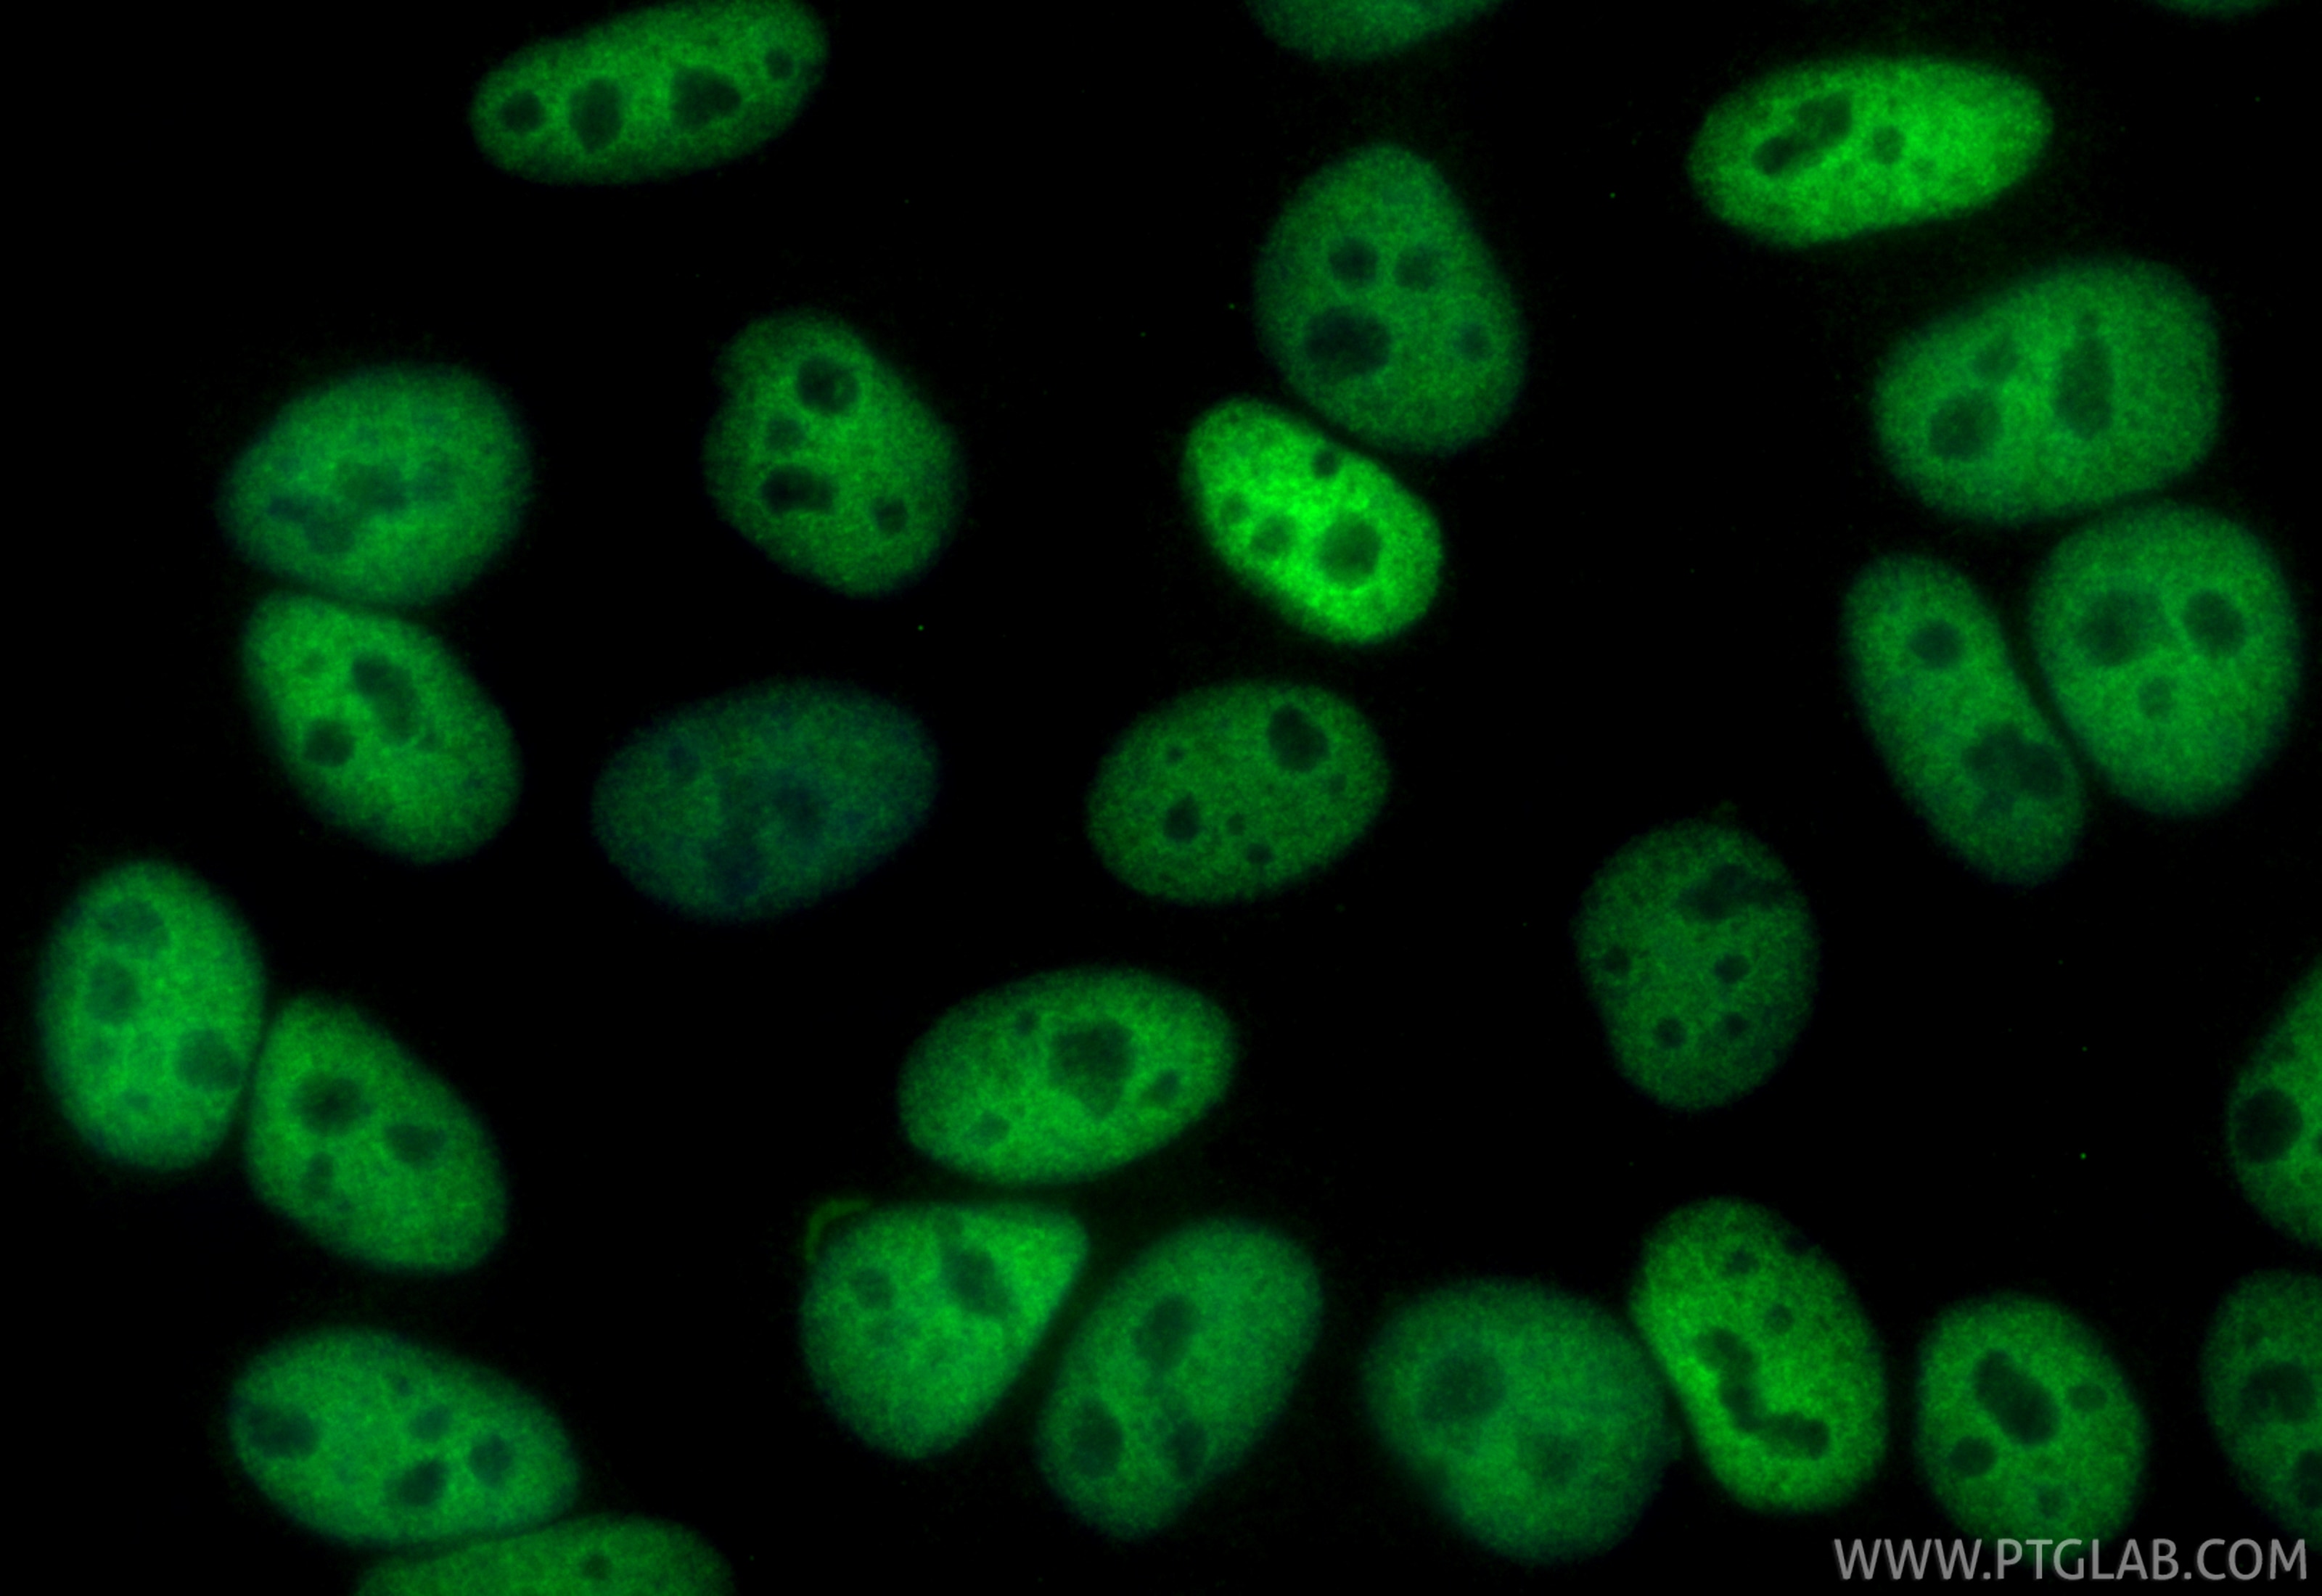
Immunofluorescence (IF) / fluorescent staining of HepG2 cells using CoraLite® Plus 488-conjugated HDAC2 Monoclonal ant (CL488-67165)

Validation Data Gallery
Tested Applications
| Positive IF/ICC detected in | HepG2 cells |
Recommended dilution
| Application | Dilution |
|---|---|
| Immunofluorescence (IF)/ICC | IF/ICC : 1:50-1:500 |
| It is recommended that this reagent should be titrated in each testing system to obtain optimal results. | |
| Sample-dependent, Check data in validation data gallery. | |
Product Information
CL488-67165 targets HDAC2 in IF/ICC applications and shows reactivity with human, mouse samples.
| Tested Reactivity | human, mouse |
| Host / Isotype | Mouse / IgG2b |
| Class | Monoclonal |
| Type | Antibody |
| Immunogen |
CatNo: Ag21288 Product name: Recombinant human HDAC2 protein Source: e coli.-derived, PET28a Tag: 6*His Domain: 274-571 aa of BC031055 Sequence: TDRVMTVSFHKYGEYFPGTGDLRDIGAGKGKYYAVNFPMRDGIDDESYGQIFKPIISKVMEMYQPSAVVLQCGADSLSGDRLGCFNLTVKGHAKCVEVVKTFNLPLLMLGGGGYTIRNVARCWTHETAVALDCEIPNELPYNDYFEYFGPDFKLHISPSNMTNQNTPEYMEKIKQRLFENLRMLPHAPGVQMQAIPEDAVHEDSGDEDGEDPDKRISIRASDKRIACDEEFSDSEDEGEGGRRNVADHKKGAKKARIEEDKKETEDKKTDVKEEDKSKDNSGEKTDTKGTKSEQLSNP 相同性解析による交差性が予測される生物種 |
| Full Name | histone deacetylase 2 |
| Calculated molecular weight | 458 aa, 52 kDa; 488 aa,55 kDa |
| Observed molecular weight | 55 kDa |
| GenBank accession number | BC031055 |
| Gene Symbol | HDAC2 |
| Gene ID (NCBI) | 3066 |
| RRID | AB_2883400 |
| Conjugate | CoraLite® Plus 488 Fluorescent Dye |
| Excitation/Emission maxima wavelengths | 493 nm / 522 nm |
| 激发激光 | Blue laser (488 nm) |
| Form | |
| Form | Liquid |
| Purification Method | Protein A purification |
| UNIPROT ID | Q92769 |
| Storage Buffer | PBS with 50% glycerol, 0.05% Proclin300, 0.5% BSA{{ptg:BufferTemp}}7.3 |
| Storage Conditions | Store at -20°C. Avoid exposure to light. Stable for one year after shipment. Aliquoting is unnecessary for -20oC storage. |
Background Information
Histone deacetylases(HDAC) are a class of enzymes that remove the acetyl groups from the lysine residues leading to the formation of a condensed and transcriptionally silenced chromatin.Histone deacetylases act via the formation of large multiprotein complexes, and are responsible for the deacetylation of lysine residues at the N-terminal regions of core histones (H2A, H2B, H3 and H4). At least 4 classes of HDAC were identified. As a class I HDAC, HDAC2 was primarily found in the nucleus. HDAC2 forms transcriptional repressor complexes by associating with many different proteins, including YY1, a mammalian zinc-finger transcription factor. Thus, it plays an important role in transcriptional regulation, cell cycle progression and developmental events. This antibody is raised against residues near the C terminus of human HDAC2.
Protocols
| Product Specific Protocols | |
|---|---|
| IF protocol for CL Plus 488 HDAC2 antibody CL488-67165 | Download protocol |
| Standard Protocols | |
|---|---|
| Click here to view our Standard Protocols |